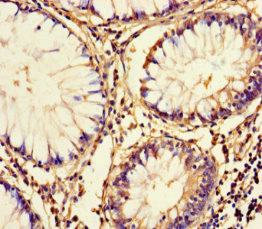

FAM161A Antibody
-
中文名稱:FAM161A兔多克隆抗體
-
貨號(hào):CSB-PA661553LA01HU
-
規(guī)格:¥440
-
圖片:
-
Western blot
All lanes: FAM161A antibody at 8µg/ml
Lane 1: Human placenta tissue
Lane 2: Mouse liver tissue
Secondary
Goat polyclonal to rabbit IgG at 1/10000 dilution
Predicted band size: 77, 65, 84 kDa
Observed band size: 77 kDa -
Immunohistochemistry of paraffin-embedded human colon cancer using CSB-PA661553LA01HU at dilution of 1:100
-
Immunohistochemistry of paraffin-embedded human lung tissue using CSB-PA661553LA01HU at dilution of 1:100
-
-
其他:
產(chǎn)品詳情
-
產(chǎn)品名稱:Rabbit anti-Homo sapiens (Human) FAM161A Polyclonal antibody
-
Uniprot No.:
-
基因名:FAM161A
-
別名:F161A_HUMAN antibody; Fam161a antibody; Family with sequence similarity 161; member A antibody; FLJ13305 antibody; Hypothetical protein LOC84140 antibody; MGC129982 antibody; MGC129983 antibody; OTTHUMP00000201353 antibody; Protein FAM161A antibody
-
宿主:Rabbit
-
反應(yīng)種屬:Human, Mouse
-
免疫原:Recombinant Human Protein FAM161A protein (1-300AA)
-
免疫原種屬:Homo sapiens (Human)
-
標(biāo)記方式:Non-conjugated
本頁(yè)面中的產(chǎn)品,F(xiàn)AM161A Antibody (CSB-PA661553LA01HU),的標(biāo)記方式是Non-conjugated。對(duì)于FAM161A Antibody,我們還提供其他標(biāo)記。見下表:
-
克隆類型:Polyclonal
-
抗體亞型:IgG
-
純化方式:>95%, Protein G purified
-
濃度:It differs from different batches. Please contact us to confirm it.
-
保存緩沖液:Preservative: 0.03% Proclin 300
Constituents: 50% Glycerol, 0.01M PBS, PH 7.4 -
產(chǎn)品提供形式:Liquid
-
應(yīng)用范圍:ELISA, WB, IHC
-
推薦稀釋比:
Application Recommended Dilution WB 1:1000-1:5000 IHC 1:20-1:200 -
Protocols:
-
儲(chǔ)存條件:Upon receipt, store at -20°C or -80°C. Avoid repeated freeze.
-
貨期:Basically, we can dispatch the products out in 1-3 working days after receiving your orders. Delivery time maybe differs from different purchasing way or location, please kindly consult your local distributors for specific delivery time.
-
用途:For Research Use Only. Not for use in diagnostic or therapeutic procedures.
相關(guān)產(chǎn)品
靶點(diǎn)詳情
-
功能:Involved in ciliogenesis.
-
基因功能參考文獻(xiàn):
- novel homozygous frameshift mutations of RP28-linked RP gene FAM161A in Indian population. PMID: 26246154
- Exome analysis revealed a nonsense homozygous mutation in FAM161A segregating with retinal degeneration with severe vision loss and a range of disease onset and progression. PMID: 25007332
- We screened a panel of 120 probands with recessive Retinitis Pigmentosa, and two were found to harbour biallelic FAM161A variants. PMID: 26113502
- founder mutation in FAM161A p.(Arg437*) underlies approximately 2% of arRP cases in the Dutch and Belgian populations. PMID: 26574802
- FAM161A's activities are probably not limited to ciliary tasks but also extend to more general cellular functions, highlighting possible novel mechanisms for the molecular pathology of retinal disease. PMID: 25749990
- Our data indicate that mutations in FAM161A are responsible for 1% of recessive RP cases in North America, similar to the prevalence detected in Germany and unlike the data from Israel and the Palestinian territories. PMID: 24651477
- Yeast two-hybrid screening of a human retinal cDNA library revealed FAM161A as a binary interaction partner of POC1B. PMID: 25018096
- an RP28 (an autosomal recessive form of retinitis pigmentosa)-linked RP family in the Palestinian population caused by a novel nonsense mutation in FAM161A, was identified. PMID: 24520187
- FAM161A is a novel centrosomal-ciliary protein that likely is implicated in the regulation of microtubule-based cellular processes in the retina. PMID: 24664697
- FAM161A-associated RP can be considered as a novel retinal ciliopathy and that its molecular pathogenesis may be related to other ciliopathies. PMID: 22940612
- FAM161A is a microtubule-associated ciliary protein presumably involved in microtubule stabilization to maintain the microtubule tracks and/or in transport processes along microtubules in photoreceptors and other retinal cell types. PMID: 22791751
- Null mutations in FAM161A are responsible for the RP28-associated autosomal-recessive retinitis pigmentosa. PMID: 20705278
- These data suggest a pivotal role for FAM161A in photoreceptors and reveal that FAM161A loss-of-function mutations are a major cause of autosomal-recessive Retinitis pigmentosa. PMID: 20705279
顯示更多
收起更多
-
相關(guān)疾病:Retinitis pigmentosa 28 (RP28)
-
亞細(xì)胞定位:Cytoplasm, cytoskeleton, cilium basal body. Cell projection, cilium. Note=Localized to the region between the outer and inner photoreceptor segments, corresponding to the photoreceptor connecting cilium.
-
蛋白家族:FAM161 family
-
組織特異性:Isoform 1 and isoform 3 are widely expressed with highest levels in retina and testis, with isoform 1 being the most abundant in all tissues tested.
-
數(shù)據(jù)庫(kù)鏈接:
Most popular with customers
-
-
YWHAB Recombinant Monoclonal Antibody
Applications: ELISA, WB, IHC, IF, FC
Species Reactivity: Human, Mouse, Rat
-
Phospho-YAP1 (S127) Recombinant Monoclonal Antibody
Applications: ELISA, WB, IHC
Species Reactivity: Human
-
-
-
-
-